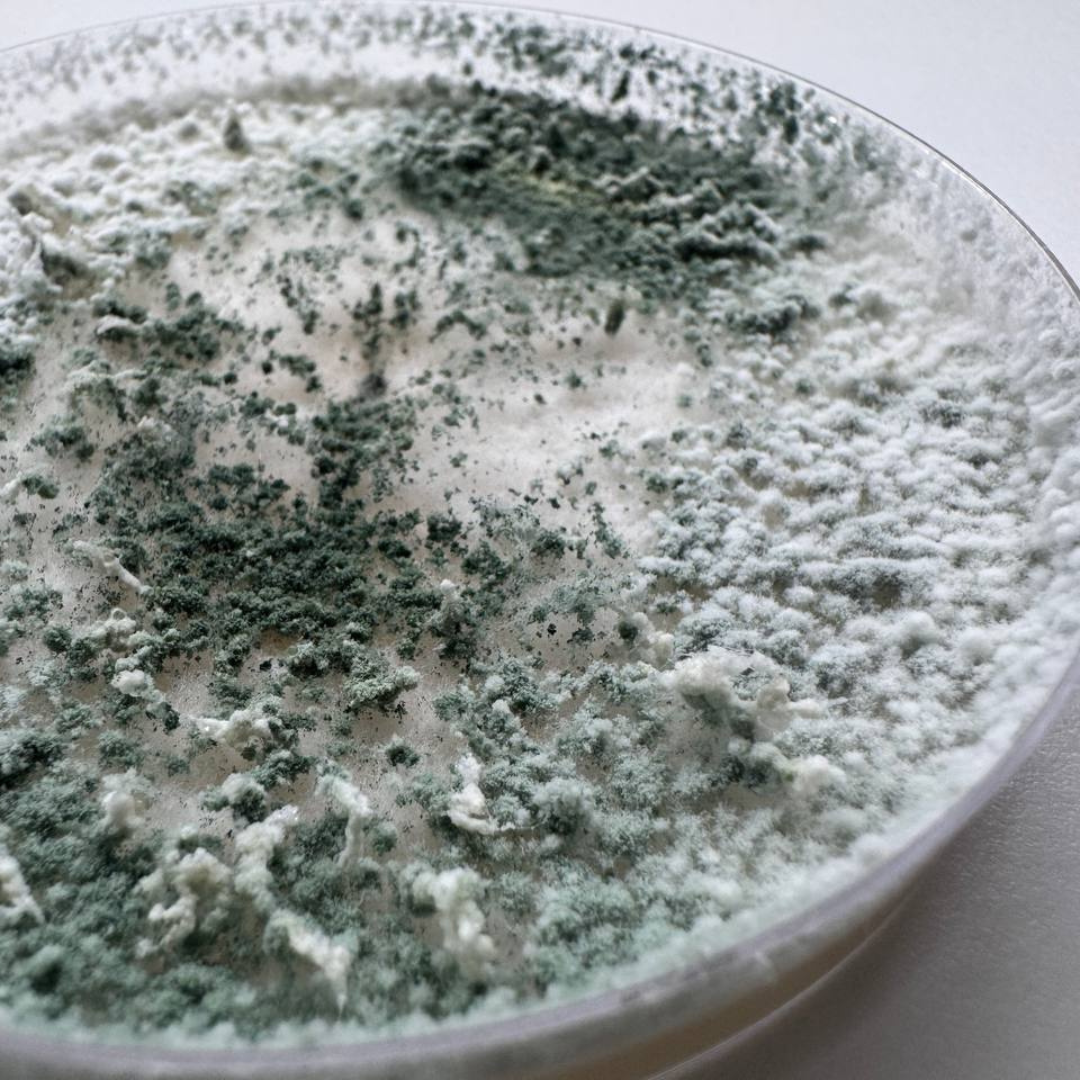

When autumn turns into late November and the soil temperature decreases, we often think that the time for active work on the plot has come to an end. However, the real, invisible work is just beginning! During this period, when nature is preparing for sleep, we have a unique opportunity to lay the foundation for the future harvest with support of the beneficial microorganisms that stay active.
Applying biological products in the fall is not a trend, but a well-founded biological strategy that launches fertility during the winter break.
It is a common mistake to think that soil bacteria and fungi stop their activity when it gets cold. In fact, when the temperature decreases, the soil remains comfortable for microorganisms to work in for a long time. And when frosts come, the microbiota does not die, it simply switches to energy-saving mode, or anabiosis.
Even at soil temperatures of around +5°C to +10°C (which is typical for a closed greenhouse before the first serious frosts), microorganisms continue to live, even if at a slower tempo.
This is the time when they can successfully colonize the root zone (rhizosphere), winning the competitive battle for a place "under the sun", or, more precisely, under the snow.
The application of biological products during this period gives our “helpers” a boost: they colonize the soil, attach themselves to organic residues, and, most importantly, start biological sanitation.
How microorganisms protect themselves from frost.
If it makes sense to apply biological products in late autumn, a logical question is: how will they survive the real winter and freezing soil?
Nature has taken care of them by arming them with powerful defense mechanisms:
Spore formation (endospores). Bacteria, such as the famous Bacillus subtilis, do not freeze. They form endospores – reliable, resistant “capsules” that can survive extreme cold, heat, radiation, and drought. Spores are an ideal “bank” of viability. As soon as the soil warms up to +8°C in spring, the spores “awaken” and the bacteria immediately begin to actively reproduce.
Spore formation (endospores). Bacteria, such as the famous Bacillus subtilis, do not freeze. They form endospores – reliable, resistant “capsules” that can survive extreme cold, heat, radiation, and drought. Spores are an ideal “bank” of viability. As soon as the soil warms up to +8°C in spring, the spores “awaken” and the bacteria immediately begin to actively reproduce.
Resistant mycelium and endophytism. Beneficial fungi, such as Trichoderma, are protected by their structure. They form a tight mycelium, which is resistant to mechanical damage and freezing thanks to its chitinous shell. But the most interesting thing is endophytism. This means that the fungus can penetrate the root cells of plants (even small root residues in the soil), where it is protected, like in a “winter apartment,” waiting for favorable conditions.
Therefore, autumn application gives microorganisms time to form these protective structures, guaranteeing their presence on the plot in spring.
The main value of autumn application of biological products (in particular, Soil Improver) is the launch of two key processes:
 1. Biological sanitation
1. Biological sanitation
Many harmful fungi stay active until the soil freezes. Applying biological products in the fall allows beneficial microorganisms (such as Trichoderma) to settle in the soil earlier and remove or significantly suppress the development of harmful spores. They create a biological shield even before you plant the first seedlings.
2. Launching the Humus Factory
Organic residues, roots, and green manure remaining in the soil are ideal food for bacteria. In a warm greenhouse, this process continues until late December. Microorganisms decompose this organic matter, converting it into readily available nutrients and valuable humus. As a result, in the spring, you will not just get soil, you will get biologically structured, loose, and nutrient-rich soil that is ready for maximum productivity.
To ensure successful wintering and an early start for your micro-helpers, follow these simple recommendations:
.png) Organic “Diet”: Always apply biological products together with something they can “eat” – this can be compost, plant debris, or green manure. This is their winter “dining room” and protective buffer.
Organic “Diet”: Always apply biological products together with something they can “eat” – this can be compost, plant debris, or green manure. This is their winter “dining room” and protective buffer.- Warm water – a gentle start: Dilute the biological product in water at a temperature of +20°C – +25°C. This will activate the spores and give them a “warm” start for their introduction into cold soil.
- Mulching – a winter blanket: After application, be sure to cover the soil with a thick layer of mulch (straw, sawdust, fallen leaves). This will protect microorganisms from sudden temperature changes and help retain heat, allowing them to continue their work.
Remember that the most successful season begins not in spring, but in autumn. By entrusting your soil to biological products, you are investing in the long-term health of your plot and guaranteeing yourself a rich harvest in the future.
 EN
EN PL
PL
